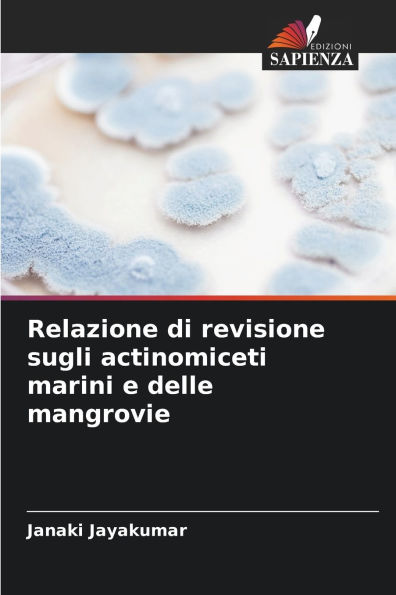
Relazione di revisione sugli actinomiceti marini e delle mangrovie

Home
Una revisione critica delle strategie Bottom-of-the-Pyramid
Barnes and Noble
Loading Inventory...
Una revisione critica delle strategie Bottom-of-the-Pyramid in Chattanooga, TN
Current price: $51.00

Barnes and Noble
Una revisione critica delle strategie Bottom-of-the-Pyramid in Chattanooga, TN
Current price: $51.00
Loading Inventory...
Size: OS
I progetti di responsabilità sociale d'impresa alla "base della piramide", ovvero nelle regioni a basso reddito del mondo, rischiano di avere vita breve o addirittura di essere dannosi per una comunità. La tesi di fondo si basa quindi sul concetto di contribuire alla riduzione della povertà incoraggiando le multinazionali a fare affari con "la base della piramide". Si sostiene che le donne, una volta emancipate come imprenditrici, produttrici, dipendenti, fornitrici o consumatrici, possono essere l'anello mancante per raggiungere sia la riduzione della povertà a lungo termine che la massimizzazione dei profitti. Alla luce dell'enorme potenziale di crescita per le multinazionali nelle zone rurali dell'Asia meridionale, la ricerca si concentra sulle campagne dell'India e del Bangladesh. Durante la stesura del libro, l'autore ha soggiornato in Bangladesh, sperimentando e osservando in prima persona le sfide e i fattori di successo delle strategie della base della piramide per far luce sul potenziale nascosto delle donne.
I progetti di responsabilità sociale d'impresa alla "base della piramide", ovvero nelle regioni a basso reddito del mondo, rischiano di avere vita breve o addirittura di essere dannosi per una comunità. La tesi di fondo si basa quindi sul concetto di contribuire alla riduzione della povertà incoraggiando le multinazionali a fare affari con "la base della piramide". Si sostiene che le donne, una volta emancipate come imprenditrici, produttrici, dipendenti, fornitrici o consumatrici, possono essere l'anello mancante per raggiungere sia la riduzione della povertà a lungo termine che la massimizzazione dei profitti. Alla luce dell'enorme potenziale di crescita per le multinazionali nelle zone rurali dell'Asia meridionale, la ricerca si concentra sulle campagne dell'India e del Bangladesh. Durante la stesura del libro, l'autore ha soggiornato in Bangladesh, sperimentando e osservando in prima persona le sfide e i fattori di successo delle strategie della base della piramide per far luce sul potenziale nascosto delle donne.